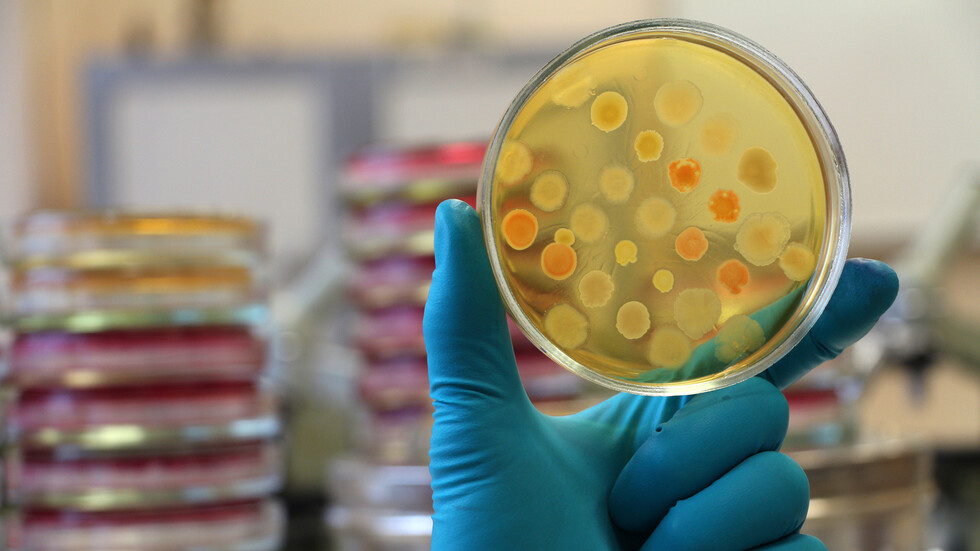
فيروسات يمكن أن تنقذ ملايين الأرواح حول العالم!

Stories
-
فيديوهات
RT STORIES
مسلحون من قبيلة بختياري يسيرون في طهران لمبايعة خامنئي
#اسأل_أكثر #Question_MoreRT STORIES
الجيش الإسرائيلي يعترض سفينة أخرى تابعة لأسطول الصمود العالمي المتجهة إلى غزة
#اسأل_أكثر #Question_MoreRT STORIES
طهران .. حفل زفاف جماعي على متن عربات عسكرية في ذكرى "زواج الإمام علي"
#اسأل_أكثر #Question_MoreRT STORIES
إصابات جراء اصطدام حافلة بعمود كهرباء في تل أبيب
#اسأل_أكثر #Question_MoreRT STORIES
لحظة إطلاق نار من سيارة أسفر عن مقتل 4 أشخاص جنوبي تركيا
#اسأل_أكثر #Question_MoreRT STORIES
لحظة هبوط اضطراي لطائرة مائية وسط أحد الشوارع الأمريكية
#اسأل_أكثر #Question_MoreRT STORIES
الآلاف يتظاهرون في صنعاء في مسيرة مليونية نصرة للقرآن والأقصى وتضامنا مع لبنان
#اسأل_أكثر #Question_MoreRT STORIES
شاهد.. أرنب بري يسقط سائق سكوتر كهربائي أثناء قفزه المفاجئ
#اسأل_أكثر #Question_MoreRT STORIES
الرئيس الإسرائيلي يتسلم أوراق اعتماد سفير صومالي لاند
#اسأل_أكثر #Question_MoreRT STORIES
المنتخب الإيراني لكرة القدم يصل تركيا استعدادا لكأس العالم
#اسأل_أكثر #Question_MoreRT STORIES
المكسيك تدمر 5 مصانع سرية للمخدرات في حملة مكافحة عصابات المخدرات
#اسأل_أكثر #Question_More
فيديوهات
-
العملية العسكرية الروسية في أوكرانيا
RT STORIES
وزير الدفاع الإستوني يعلن إسقاط مسيرة يرجح أنها أوكرانية
#اسأل_أكثر #Question_MoreRT STORIES
الجيش الروسي يسيطر على بلدة في خاركوف
#اسأل_أكثر #Question_MoreRT STORIES
مدفيديف ردا على دول البلطيق: كلما صغر الحجم كان النباح أعلى
#اسأل_أكثر #Question_MoreRT STORIES
"إحداثياتكم معروفة والناتو لن يحميكم".. روسيا تحذر لاتفيا من تحويل أراضيها منصة لمسيرات أوكرانية
#اسأل_أكثر #Question_MoreRT STORIES
هجوم أوكراني ليلي مكثف على إنيرغودار وسط تطمينات بسلامة المفاعل النووي
#اسأل_أكثر #Question_MoreRT STORIES
ميروشنيك: أوكرانيا تشن هجومها الأعنف بالمسيرات على موسكو
#اسأل_أكثر #Question_MoreRT STORIES
أسير كولومبي: القوات الأوكرانية طالبتني بأكثر من 10 آلاف دولار بعد إبلاغهم برغبتي في العودة إلى بلدي
#اسأل_أكثر #Question_MoreRT STORIES
الرئيس الصربي: روسيا لم تستخدم إلا جزءا من ترسانتها خلال عمليتها العسكرية الخاصة في أوكرانيا
#اسأل_أكثر #Question_MoreRT STORIES
ميرتس يوجّه رسالة مزدوجة إلى بوتين بشأن مسار الحوار
#اسأل_أكثر #Question_MoreRT STORIES
محطة زابوروجيه النووية تؤكد عدم وجود أضرار جوهرية بعد الهجوم الأوكراني
#اسأل_أكثر #Question_MoreRT STORIES
باسيتشنيك: مقتل فتاة جراء قصف مسيرة جوية أوكرانية لحافلة مدنية في لوغانسك
#اسأل_أكثر #Question_MoreRT STORIES
وزير الخارجية التركي: الصراع في أوكرانيا يتسبب في أضرار جسيمة لأوروبا
#اسأل_أكثر #Question_MoreRT STORIES
ليبيديف: قصف قوي قرب أوديسا على تجمع لمدربين فرنسيين متورطين في الهجمات على روسيا
#اسأل_أكثر #Question_MoreRT STORIES
"لا ترتكبوا هذا الخطأ الجسيم معه".. ميركل تقدم نصيحة للسياسيين الأوروبيين تخص بوتين
#اسأل_أكثر #Question_MoreRT STORIES
مرتزق كولومبي يدعو مواطني بلاده إلى عدم القتال في صفوف القوات الأوكرانية
#اسأل_أكثر #Question_MoreRT STORIES
الدفاع الأوكرانية تشتري دفعة تجريبية من قنابل جوية موجهة محلية الصنع
#اسأل_أكثر #Question_MoreRT STORIES
الدفاع الروسية: هجوم مكثف على صناعات ومطارات عسكرية في أوكرانيا ومواقع بنية تحتية مرتبطة بجيشها
#اسأل_أكثر #Question_More
العملية العسكرية الروسية في أوكرانيا
-
زيارة بوتين إلى الصين
RT STORIES
بكين مرحبة بزيارة بوتين: نحن على ثقة بأن الصداقة الصينية الروسية ستزداد رسوخا
#اسأل_أكثر #Question_MoreRT STORIES
مانتوروف: روسيا والصين تستعيدان الديناميكية الإيجابية للتبادل التجاري خلال 2026
#اسأل_أكثر #Question_MoreRT STORIES
بوتين: العلاقات الروسية الصينية بلغت مستوى غير مسبوق
#اسأل_أكثر #Question_MoreRT STORIES
أوشاكوف: رئيسا روسيا والصين سيتبنيان إعلانا حول إقامة عالم متعدد الأقطاب
#اسأل_أكثر #Question_MoreRT STORIES
أوشاكوف يعلق على "المواعيد المتقاربة" لزيارتي بوتين وترامب إلى الصين
#اسأل_أكثر #Question_MoreRT STORIES
"الغارديان": الغرب قلق إزاء تعزيز العلاقات بين روسيا والصين
#اسأل_أكثر #Question_MoreRT STORIES
موسكو وبكين تحتفلان بثلاثين عاما من الشراكة خلال قمة بوتين - شي
#اسأل_أكثر #Question_MoreRT STORIES
استخباراتي أمريكي: الصين ترحب دائما ببوتين على خلاف ترامب
#اسأل_أكثر #Question_More
زيارة بوتين إلى الصين
-
نبض الملاعب
RT STORIES
ضربة قوية لإسبانيا.. لامين جمال يغيب عن بداية المونديال بمواجهتي الرأس الأخضر والسعودية
#اسأل_أكثر #Question_MoreRT STORIES
عودة الوحش.. ليسنر يسحق أوبا فيمي في مواجهة مثيرة
#اسأل_أكثر #Question_MoreRT STORIES
تصرف صادم في هامبورغ.. لاعب تنس يخلع ملابسه أثناء المباراة
#اسأل_أكثر #Question_MoreRT STORIES
نيمار ينفجر فرحا في بث مباشر بعد العودة لمنتخب البرازيل
#اسأل_أكثر #Question_MoreRT STORIES
زينيت يشعل شوارع بطرسبورغ بموكب التتويج والكأس الذهبية
#اسأل_أكثر #Question_MoreRT STORIES
بالفيديو.. رد فعل هستيري لعائلة ويفرتون بعد حلم المونديال
#اسأل_أكثر #Question_MoreRT STORIES
محرز يرد على شائعات الرحيل ويكشف موقفه النهائي من الأهلي السعودي
#اسأل_أكثر #Question_MoreRT STORIES
مفاجأة.. غوارديولا يتخذ قرارا حاسما بشأن مستقبله مع مانشستر سيتي
#اسأل_أكثر #Question_MoreRT STORIES
"كاف" يعلن تصنيف المنتخبات قبل قرعة تصفيات كأس أمم إفريقيا
#اسأل_أكثر #Question_MoreRT STORIES
"وداع مؤثر في أنفليد".. ليفربول يعلن موعد التكريم الخاص لمحمد صلاح وروبرتسون
#اسأل_أكثر #Question_More
نبض الملاعب
-
هدنة وحصار المضيق
RT STORIES
بينها وقف الحرب على جبهة لبنان.. إيران تعرض مقترحها الأخير للتفاوض مع واشنطن
#اسأل_أكثر #Question_MoreRT STORIES
الأسباب الحقيقية وراء تأجيل ترامب مهاجمة إيران مجددا
#اسأل_أكثر #Question_MoreRT STORIES
ترامب يشن هجوما جديدا: حتى لو استسلمت إيران بالكامل سيحتفل الإعلام "الفاسد" بانتصارها
#اسأل_أكثر #Question_MoreRT STORIES
طهران: الولايات المتحدة أبدت مرونة بشأن البرنامج النووي
#اسأل_أكثر #Question_More
هدنة وحصار المضيق
-
لحظة بلحظة.. تحت غطاء "وقف النار" إسرائيل تواصل عملياتها في لبنان
RT STORIES
لحظة بلحظة.. تحت غطاء "وقف النار" إسرائيل تواصل عملياتها في لبنان
#اسأل_أكثر #Question_More -
الصحة اللبنانية: 3020 قتيلا و9273 جريحا حصيلة العدوان الإسرائيلي منذ 2 مارس
RT STORIES
الصحة اللبنانية: 3020 قتيلا و9273 جريحا حصيلة العدوان الإسرائيلي منذ 2 مارس
#اسأل_أكثر #Question_More
اكتشاف آلاف الفيروسات الجديدة في المحيط!
حُدّد أكثر من 5000 نوع جديد من الفيروسات في محيطات العالم، وفقا لدراسة جديدة.
وحلل الباحثون في الدراسة عشرات الآلاف من عينات المياه من جميع أنحاء العالم، بحثا عن فيروسات الحمض النووي الريبي، أو الفيروسات التي تستخدم الحمض النووي الريبي كمواد جينية. ويعد فيروس كورونا الجديد، على سبيل المثال، نوعا من فيروسات الحمض النووي الريبي. وقال المعدون إن هذه الفيروسات لم تُدرس جيدا مقارنة بفيروسات الحمض النووي، التي تستخدم الحمض النووي كمواد جينية.
وكان تنوع الفيروسات المكتشفة حديثا كبيرا لدرجة أن الباحثين اقترحوا مضاعفة عدد المجموعات التصنيفية اللازمة لتصنيف فيروسات الحمض النووي الريبي، من الشعب الخمس الحالية إلى 10 شُعب.
وقال المعد الرئيسي للدراسة ماثيو سوليفان، أستاذ علم الأحياء الدقيقة في جامعة ولاية أوهايو، في بيان: "هناك الكثير من التنوع الجديد - وعثر على شعبة جديدة بالكامل، Taraviricota، في جميع أنحاء المحيطات، ما يشير إلى أنها مهمة من الناحية البيئية".
ووفقا لسوليفان، ركزت الدراسات التي أجريت على فيروسات الحمض النووي الريبي عادة على تلك التي تسبب الأمراض. (تشمل بعض فيروسات الحمض النووي الريبي المعروفة الإنفلونزا والإيبولا والفيروس التاجي المسبب لـ "كوفيد-19"). لكن هذه ليست سوى "شريحة صغيرة" من فيروسات الحمض النووي الريبي على الأرض.
وقال سوليفان في البيان "أردنا دراستها بشكل منهجي على نطاق واسع للغاية واستكشاف بيئة لم ينظر إليها أحد بعمق".
فيروسات يمكن أن تنقذ ملايين الأرواح حول العالم!
وبالنسبة للدراسة، التي نُشرت يوم الخميس 7 أبريل في مجلة Science، حلل الباحثون 35000 عينة مياه مأخوذة من 121 موقعا في جميع محيطات العالم الخمسة. والباحثون جزء من اتحاد Tara للمحيطات، وهو مشروع عالمي لدراسة تأثير تغير المناخ على المحيط.
وقال الباحثون إنهم فحصوا التسلسلات الجينية المستخرجة من الكائنات المائية الصغيرة المعروفة باسم العوالق، والتي تعد مضيفا شائعا لفيروسات الحمض النووي الريبي. واستقروا على تسلسلات تنتمي إلى فيروسات RNA من خلال البحث عن جين قديم يسمى RdRp، والذي يوجد في جميع فيروسات RNA ولكنه غائب عن الفيروسات والخلايا الأخرى. وحددوا أكثر من 44000 تسلسل مع هذا الجين.
لكن جين RdRp عمره مليارات السنين، وتطور عدة مرات. ولأن تطور الجين يعود إلى الوراء، كان من الصعب على الباحثين تحديد العلاقة التطورية بين التسلسلات. لذلك استخدم الباحثون التعلم الآلي للمساعدة في تنظيمهم.
وبشكل عام، حددوا حوالي 5500 نوع جديد من فيروسات الحمض النووي الريبي التي وقعت في الفئات الخمس الموجودة، بالإضافة إلى الفئات الخمس المقترحة حديثا، والتي أطلق عليها Taraviricota وPomiviricota وParaxenoviricota وWamoviricota وArctiviricota.
وكانت أنواع الفيروسات في فصيلة Taraviricota وفيرة بشكل خاص في المياه المعتدلة والاستوائية، في حين أن الفيروسات في Arctiviricota phylum وفيرة في المحيط المتجمد الشمالي، كما كتب الباحثون في The Conversation.
وقالوا إن فهم كيفية تباين جين RdRp بمرور الوقت يمكن أن يؤدي إلى فهم أفضل لكيفية تطور الحياة المبكرة على الأرض.
وقال المعد الأول المشارك في الدراسة أحمد زايد، عالم أبحاث في علم الأحياء الدقيقة بولاية أوهايو، في البيان: "من المفترض أن يكون RdRp أحد أقدم الجينات - فقد كان موجودا قبل أن تكون هناك حاجة للحمض النووي. لذلك نحن لا نتتبع فقط أصول الفيروسات، ولكننا نتتبع أيضا أصول الحياة".
المصدر: لايف ساينس
التعليقات